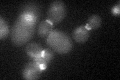
YIL140W
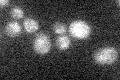
YIL140W

View description
Integral plasma membrane protein required for axial budding in haploid cells, localizes to the incipient bud site and bud neck; glycosylated by Pmt4p; potential Cdc28p substrate
Localization:
Intensity:
Fold change:
Significance:
-
C’ GFP library in SD
bud neckN/A -
N' NOP1pr-GFP in SD

vacuole45.3431 -
N' TEF2pr-mCherry in SD

vacuole23.8931 -
N' NATIVEpr-GFP in SD

ambiguous22.4515 -
N' TEF2pr-VC and Cyto-VN in SD

#N/A0 -
C’ GFP library in SD+DTT

bud neck21.470.99No -
C’ GFP library in SD+H2O2

bud neck21.250.98No -
C’ GFP library in Starvation Media
bud neck18.10.83No -
C’ GFP library on the background of Pup2-DaMP

bud neck -
C’ GFP library on the background of CCT mutant

bud neck16.6360.771699No
